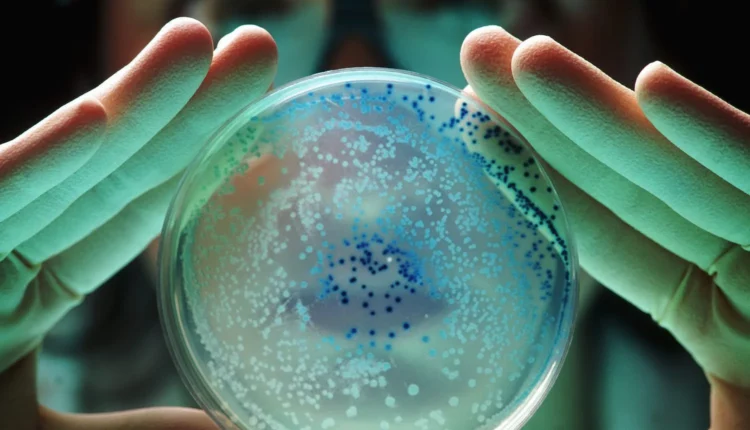

Πρωτεΐνη σχεδιασμένη από AI μπλοκάρει βακτήρια ανθεκτικά στα αντιβιοτικά
Αυστραλοί επιστήμονες από το Πανεπιστήμιο Monash και άλλα ιδρύματα, με τη βοήθεια της τεχνητής νοημοσύνης (AI), ανέπτυξαν μια πρωτεΐνη ικανή να εξουδετερώσει βακτήρια ανθεκτικά στα αντιβιοτικά, όπως το Escherichia coli.
Η μελέτη, που δημοσιεύτηκε πρόσφατα στο περιοδικό Nature Communications με τίτλο «Inhibiting heme piracy by pathogenic Escherichia coli using de novo-designed proteins», έδειξε πώς η πρωτεΐνη αυτή μπλοκάρει τον μεμβρανικό μεταφορέα ChuA, ο οποίος τα βακτήρια χρησιμοποιούν για να δεσμεύουν αιμογλοβίνη, να εξάγουν το απαραίτητο συνένζυμο ήμη και να το εισάγουν στο εσωτερικό τους, προκειμένου να αναπτυχθούν.
Οι ερευνητές, με προεξάρχοντες τους Dr. Rhys Grinter και Gavin Knott, χρησιμοποίησαν μια πλατφόρμα AI με βάση την τεχνολογία που έχει αναπτύξει ο Βραβευμένος με Νόμπελ David Baker, αξιοποιώντας ελεύθερα διαθέσιμα αλλά και δικά τους εργαλεία σχεδιασμού πρωτεϊνών. Με τη χρήση τεχνικών μοντελοποίησης, κρυο-ηλεκτρονικής μικροσκοπίας (Cryo-EM), ακτινικής κρυσταλλογραφίας, μεταλλαξιογένεσης και φαινοτυπικής ανάλυσης, σχεδίασαν συνδετικά μόρια που παρεμποδίζουν τον δεσμό της αιμογλοβίνης με τον μεταφορέα ChuA.
Αυτά τα συνδετικά αναστέλλουν αποτελεσματικά την ανάπτυξη του E. coli σε πολύ χαμηλές συγκεντρώσεις νανομόριας (nanomolar). Η δομή των συνδετικών επιβεβαιώθηκε μέσω κρυσταλλογραφίας, επιβεβαιώνοντας την υψηλή συγγένεια και αποτελεσματικότητα ως αναστολείς της εξαγωγής του ήμη.
Η έρευνα δείχνει τη δύναμη των πρωτεϊνών σχεδιασμένων de novo με τη βοήθεια της AI να αναστείλουν κρίσιμες λειτουργίες βακτηρίων παρεμποδίζοντας τη λήψη ζωτικών θρεπτικών συστατικών, ανοίγοντας το δρόμο για την ανάπτυξη νέων φαρμακευτικών ουσιών που στοχεύουν μεμβρανικούς μεταφορείς όχι μόνο σε βακτήρια αλλά και σε άλλους οργανισμούς.
Η πλατφόρμα AI Protein Design που ανέπτυξαν οι επιστήμονες στην Αυστραλία, με κόμβους στα Ινστιτούτα Βιοϊατρικής Ανακάλυψης (Bio21 Institute και Monash), φέρνει τη χώρα στην πρωτοπορία της διεθνούς βιοτεχνολογίας, επιταχύνοντας την ανάδειξη αποτελεσματικών θεραπειών έναντι της ανερχόμενης κρίσης των ανθεκτικών στα αντιβιοτικά μικροβίων.
Ο John Carroll, διευθυντής του Monash Biomedicine Discovery Institute, υπογράμμισε ότι η έρευνα αυτή αναδεικνύει το πλεονέκτημα της καινοτομίας AI στο σχεδιασμό πρωτεϊνών, ευχαριστώντας την επιμονή και το επιχειρηματικό πνεύμα των νέων επιστημόνων που έκαναν αυτό το εγχείρημα πραγματικότητα.
Η μελέτη σηματοδοτεί μια νέα εποχή όπου οι πρωτεΐνες σχεδιασμένες από AI θα μπορούν να δημιουργηθούν γρήγορα και οικονομικά, ανοίγοντας το δρόμο για θεραπείες, εμβόλια και διαγνωστικά εργαλεία που αλλάζουν το τοπίο της ιατρικής.
[via]
